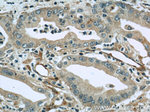
Radixin Antibody in Immunohistochemistry (Paraffin) (IHC (P))
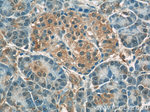
Radixin Antibody in Immunohistochemistry (Paraffin) (IHC (P))

Search
Proteintech
Radixin Polyclonal Antibody
{{$productOrderCtrl.translations['antibody.pdp.commerceCard.promotion.promotions']}}
{{$productOrderCtrl.translations['antibody.pdp.commerceCard.promotion.viewpromo']}}
{{$productOrderCtrl.translations['antibody.pdp.commerceCard.promotion.promocode']}}: {{promo.promoCode}} {{promo.promoTitle}} {{promo.promoDescription}}. {{$productOrderCtrl.translations['antibody.pdp.commerceCard.promotion.learnmore']}}
产品信息
13790-1-AP
种属反应
已发表种属
宿主/亚型
分类
类型
抗原
偶联物
形式
浓度
规格
纯化类型
保存液
内含物
保存条件
运输条件
产品详细信息
Immunogen sequence: MPKPINVRV TTMDAELEFA IQPNTTGKQL FDQVVKTVGL REVWFFGLQY VDSKGYSTWL KLNKKVTQQD VKKENPLQFK FRAKFFPEDV SEELIQEITQ RLFFLQVKEA ILNDEIYCPP ETAVLLASYA VQAKYGDYNK EIHKPGYLAN DRLLPQRVLE QHKLTKEQWE ERIQNWHEEH RGMLREDSMM EYLKIAQDLE MYGVNYFEIK NKKGTELWLG VDALGLNIYE HDDKLTPKIG FPWSEIRNIS FNDKKFVIKP IDKKAPDFVF YAPRLRINKR ILALCMGNHE LYMRRRKPDT IE (1-301 aa encoded by BC047109)
靶标信息
Radixin is a cytoskeletal protein that may be important in linking actin to the plasma membrane. It is highly similar in sequence to both ezrin and moesin. The radixin gene has been localized by fluorescence in situ hybridization to 11q23. A truncated version representing a pseudogene (RDXP2) was assigned to Xp21.3. Another pseudogene that seemed to lack introns (RDXP1) was mapped to 11p by Southern and PCR analyses. Multiple alternatively spliced transcript variants encoding different isoforms have been found for this gene. [provided by RefSeq, May 2012]
仅用于科研。不用于诊断过程。未经明确授权不得转售。
生物信息学
蛋白别名: ESP10; Radixin; radixin isoform; unnamed protein product
基因别名: AA516625; DFNB24; RDX
UniProt ID: (Human) P35241, (Mouse) P26043
Entrez Gene ID: (Human) 5962, (Rat) 315655, (Mouse) 19684